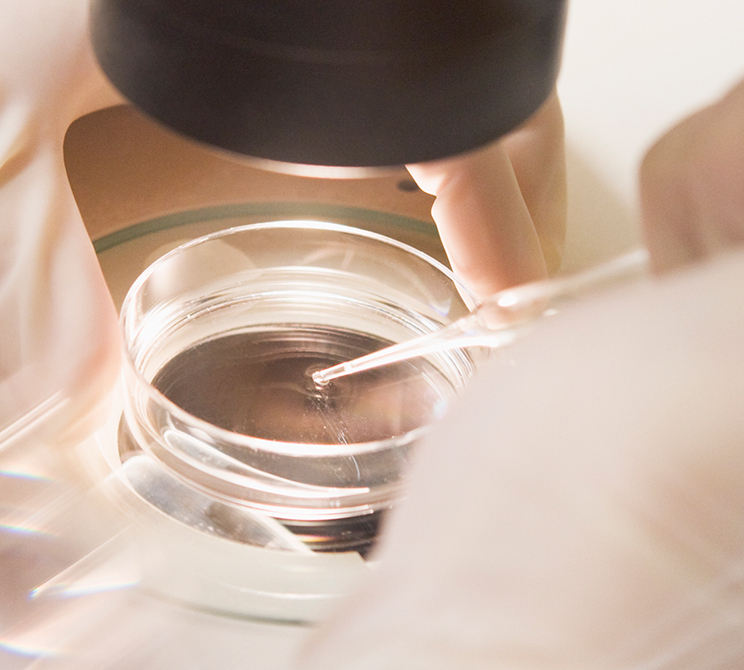
Behind the Scenes in the Boston IVF Labs | Preparing for an IVF Cycle

Treatments
Treatments
Explore our fertility treatments and how they can support your journey
Treatment for everyone
For people experiencing
Donor & Surrogacy
Fertility Preservation
What to Expect
What to Expect
Learn what to expect at Boston IVF visits, understand insurance coverage, and more.
Leading Science
Leading Science
Discover how Boston IVF's advanced science, labs, and research drive patient success.
Pioneering Science
Doctors and Experts
Doctors and Experts
Meet the team of Boston IVF doctors, scientists, and clinicians guiding you on your path to parenthood.
Doctors & Experts
Wellness Center
Wellness Center
Learn how our wellness center services can complement your care during fertility treatment.
Promoting Fertility Through Mind and Body Health
Resources
Resource Center
Discover comprehensive advice and educational resources to support you before and through your fertility treatment journey
Resource Center Tags
- Featured
- About Boston IVF
- Events
- In The News
- Advocacy
- Fertility Support
- Press Releases
- Real Patient Stories
- How to Get Started
- General Fertility
- Diagnosis & Testing
- While in Treatment
- Embryos & Lab Science
- Male Fertility
- LGBTQ+ Family Building
- Lifestyle & Nutrition
- Emotional Support
- Insurance & Fertility Financing

 NEW ENGLAND: (888) 300-2483
NEW ENGLAND: (888) 300-2483